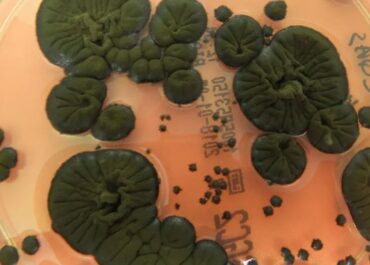

Місія Artemis II успішно повернулася на Землю після польоту навколо Місяця
Капсула космічного корабля Orion із екіпажем місії Artemis II успішно повернулася на Землю після завершення польоту навколо Місяця. Приводнення відбулося у Тихому океані біля узбережжя США о 03:09 за київським…Продовжити читання →